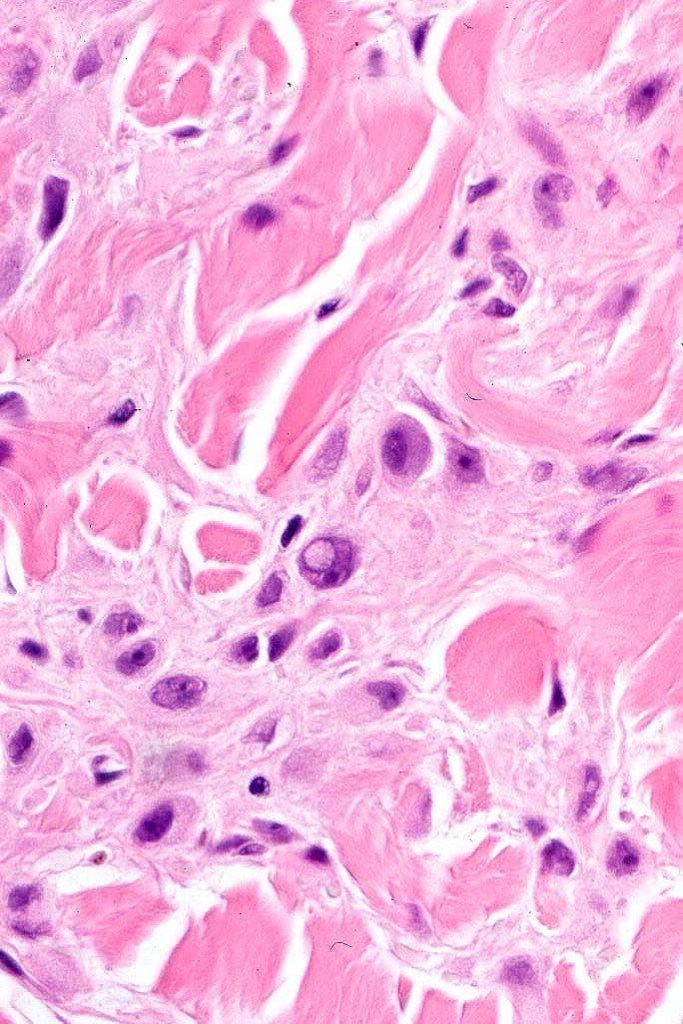

Although desmoplasia may exceptionally be encountered in banal/common and congenital nevi, the overwhelming majority of cases represent sclerosis in Spitz nevi. Desmoplastic blue neves is discussed in a separate blog. Desmoplastic nevus arising on chronic sun-damaged skin has also been described.
Clinical features
Desmoplastic Spitz nevus presents as a usually small, erythematous papule or nodule on the extremities of younger adult patients (commonest in the 3rd decade).
Histological features and immunohistochemistry
•Hyperkeratosis
•The epidermis is generally normal although sometimes acanthosis is evident
•Silhouette is either wedge-shaped or plaque-like
•Residual Spitzoid junctional nests sometimes evident
•In some cases, nested collections of spindle or epithelioid cells are present in the superficial dermis
•For the most part, the lesion is composed of somewhat pleomorphic, spindled or epithelioid cells with often abundant eosinophilic cytoplasm & vesicular nuclei with small nucleoli. Melanin is either sparse or absent
•Intranuclear cytoplasmic pseudoinclusions are generally present
•With increasing depth (or age of the lesion), the nevus cells are separated by a dense, sclerotic stroma
•Mitoses are either absent or ocassionally 1 or at most 2 may be seen
•In addition to S100, HMB45 is sometimes positive
•P16 +ve

Differential diagnosis
In the overwhelming majority of cases, the diagnosis is straighforward.
Very occasionally, epithelioid fibrous histiocytoma enters the differential diagnosis. Distinction is most readily afforded by immunohistochemistry. The latter charcateristically shows ALK expression and is negative for S100 and HMB45.
Desmoplastic melanoma typically arises on sun damaged skin. In situ melanoma or atypical lentiginous hyperplasia is generally evident and the tumor cells are basophilic and the nuclei hyperchromatic. Deep extension, lymphoid aggregates, mitoses and perineural infiltration are additional histological discriminants. Desmoplastic melanoma is generally p16 -ve.
Leave a comment